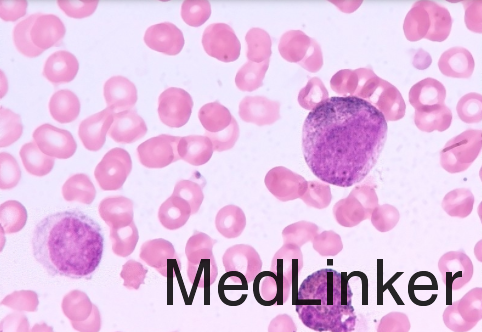

下载或打开 医联APP 查看完整评论
立即下载
打开APP
AML-M3一例
主诉 病史
患者男性,32岁,因皮肤青紫及进行性鼻出血就诊。患者诉轻微碰伤后即出现皮肤青紫,伴鼻出血进行性加重2周就诊于|急诊室。3周来体重下降9kg,伴夜间大汗及发热
查体 辅查
T 39.7℃,P120次/分,BP150/80mmHg。头颅和五官:无黄疸,无外周淋巴结肿大。胸部:双侧肺部听诊呼吸音清。腹部:腹软,无触痛,可触及脾脏边缘。皮肤:弥漫性瘀斑。 血常规:血红蛋白12.1g/dl,血小板31000/μl,白细胞67000/μl。生化全套:未见异常。D-二聚体>20,纤维蛋白原117,纤维蛋白原裂解产物160(升高)。外周血涂片:血小板明显减少,可见大量的幼稚髓系细胞。骨髓穿刺:可见幼稚髓系细胞,细胞核呈裂隙状、折叠状(见图)。 细胞遗传学检查:t(15;17)易位。
诊断 处理
诊断:畸形早幼粒细胞白血病 治疗:ATRA化疗
随访 讨论
AML-M3预后良好,ATRA已被广泛认为可以明显改善患者的无病生存率,但患者经过诱导治疗达到完全缓解后,必须给予2-3周期的蒽环类药物作为缓解后治疗,其目的是完全清楚白血病克隆,通过PCR确定患者达到分子生物学缓解预示预后良好。
发布于 15-11-09 23:20
